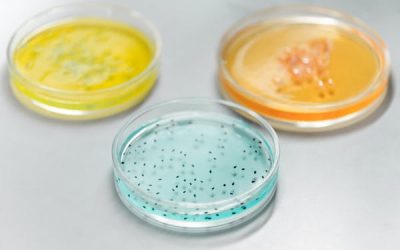
Depression or something else?

Blog
Each month, we offer a more detailed look of the health issues women in today’s world face. We hope you find articles to help and assist you in being your best self.
Life at 60
Let's talk about all you seasoned and mature women out there. You've been through many transitional phases in life and survived the dreaded 'mid-life' crisis! Menopause is behind you, at least the hot flashes and hormone shifts and you are settling in to a life where...
Urinary Incontinence
Sometimes, all you ever hear about is how crummy it is to get old! Did you know that urinary incontinence is not a natural part of aging? Female incontinence can range from minor leaking with a cough or sneeze, to a sudden urge to urinate, and unable to make it to the...
Is it labor or not?
Pregnancy brings with it so many unknowns and new experiences. Whether you are experiencing your first pregnancy or your sixth, each one can vary greatly. First time moms can have an especially difficult time as they navigate this new world. Contractions and...
Depression or something else?
There's been a recent shift in the world of diagnosing and treating depression. Many scientist and medical studies are concluding, through years of research that there is a strong relationship between the gut microbiome, inflammation and our brain health. The studies...
Hormones…the ones we love to hate,
Oh ya...and blame on all of our weight problems and everything else. If you spend any amount of time on social media, odds are, you have heard the babble about hormones. There are some wild claims that if your hormones are out of whack, it will be impossible to lose...
A Habitat of Happiness
Albert Einstein said, “Not everything that can be counted counts and not everything that counts can be counted.” You count the hours in a day, the days in a month, the months in a year. You can count calories in and calories out. You can count the minutes spent on a...
Tired… All. The. Time
It almost feels like an epidemic...being tired all the time; bone tired even though we are sure we get a full 8 hours or more of sleep a night. So, what gives? Why are we all so tired? The world has become a toxic place to reside. We are surrounded by chemicals every...
Foundations of health
When it comes to taking care of ourselves, the information out there is endless and confusing…Is Keto the right diet or does it actually damage your liver. Is caffeine a health food or does it destroy your gut. Honestly, you can find any information supporting or...
The pains of labor
One of the hardest parts about finding out you are pregnant, especially for first time moms, is the anticipation of labor. Because it is one of the great unknowns, thoughts of this process can be overwhelming and even scary. Every woman's experience differs greatly...
Infertility…now what?
Unless you are one who is, or has had to deal with fertility issues, it's not something we think about very often, yet, it seems as though fertility issues are on the rise. You don't have to look far to find someone going through a similar infertility journey as you....
Why Choose Us
Over 30 Years of Experience
Having a trusting healthcare provider is one the best ways to show a little self-love and care. Our providers are continually improving their knowledge and expertise to stay current in the best way to care for you.
Excellent Service
When you team up with Madison Women’s Clinic, your care will be personalized and meaningful to you.
Care For All Ages
We are here to care for the total health of women in all age groups. Whether you are just embarking on motherhood or navigating the emotional terrain of menopause, we are here to guide you with each step of the way.
Reach Us
Our Office
15 Madison Professional Park
Rexburg, Idaho 83440
208-356-6185
Hours
M-Th: 8:30am - 4:30
If you have an emergency after hours, call our office and our after hours nurse will help you.